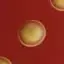

纠纷处理及不良内容举报电话:
4006600910 (工作时间: 9:00-12:30,14:00-18:00)
北京市朝阳区启阳路4号院2号楼15层1803室
抵制不良游戏 拒绝盗版游戏
注意自我保护 谨防受骗上当
适度游戏益脑 沉迷游戏伤身
合理安排时间 享受健康生活

🔥 热门游戏圈

233角色社区
帖子 3418489·新增 857

樱花校园论坛
帖子 1030388·新增 154

交友生活论坛
帖子 850830·新增 2564

迷你世界
帖子 725521·新增 88

蛋仔派对
帖子 552133·新增 230

逃跑少年聚集地
帖子 295920·新增 67

夜色酒吧(鱿鱼丝游戏)
帖子 256567·新增 14

米加小镇世界
帖子 233615·新增 57

热门游戏攻略
帖子 204213·新增 571

233造物岛社区
帖子 167580·新增 21
下载233乐园APP
专心推荐好游戏
纠纷处理及不良内容举报电话:
4006600910 (工作时间: 9:00-12:30,14:00-18:00)
北京市朝阳区启阳路4号院2号楼15层1803室
抵制不良游戏 拒绝盗版游戏
注意自我保护 谨防受骗上当
适度游戏益脑 沉迷游戏伤身
合理安排时间 享受健康生活